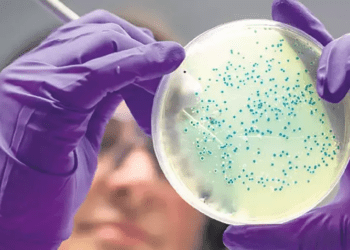
Araştırma: Bazı bakteriler vampir gibi
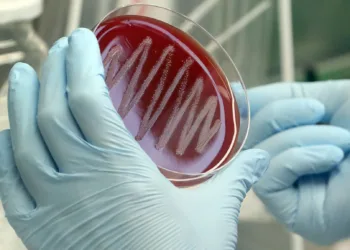
Strep A belirtileri neler, bakteri hangi hastalıklara yol açıyor?

Yapay zeka, ilaca dirençli bakterilere karşı yeni antibiyotik tasarladı
BBC‘nin haberine göre Massachusetts Teknoloji Enstitüsü (MIT) ekibi gözetiminde yapay zeka tarafından atom atom tasarlanan iki ilaç, laboratuvarda ve hayvanlar ...
Devamını okuDetails